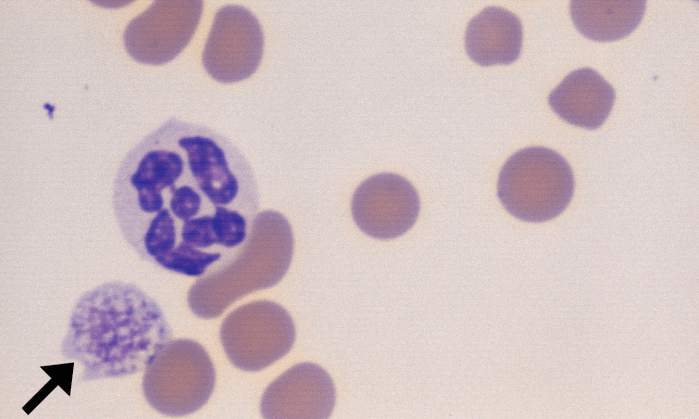
Giant Platelets 3 (Canine 3) ARROWS

Giant Platelet

Also called: macroplatelet
Morphology: very large platelets (larger than red blood cells). Morphology may be normal or abnormal depending on underlying cause.
Clinical relevance: giant platelets are often (but not always) immature platelets produced in response to peripheral causes of thrombocytopenia. Giant platelets may be observed in healthy animals (most common in cats). Giant platelets may also result from congential disorders (inherited macrothrombocytopenias).